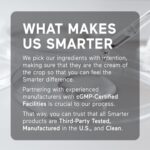

Price: $12.99
(as of Apr 04,2026 07:17:28 UTC – Details)

To calculate the overall star rating and percentage breakdown by star, we don’t use a simple average. Instead, our system considers things like how recent a review is and if the reviewer bought the item on Amazon. It also analyzed reviews to verify trustworthiness.Learn more how customers reviews work on Amazon

![SMARTERNUTRITION Essential Amino Acids (EAA) Capsules - 1 Gram Per Serving of All 9 EAAs - Supports Muscle Mass & Exercise - Non-GMO, Vegan, Gluten Free - 60 Count[30-Day Supply]](https://m.media-amazon.com/images/I/41D-5JBIs+L._AC_.jpg)










